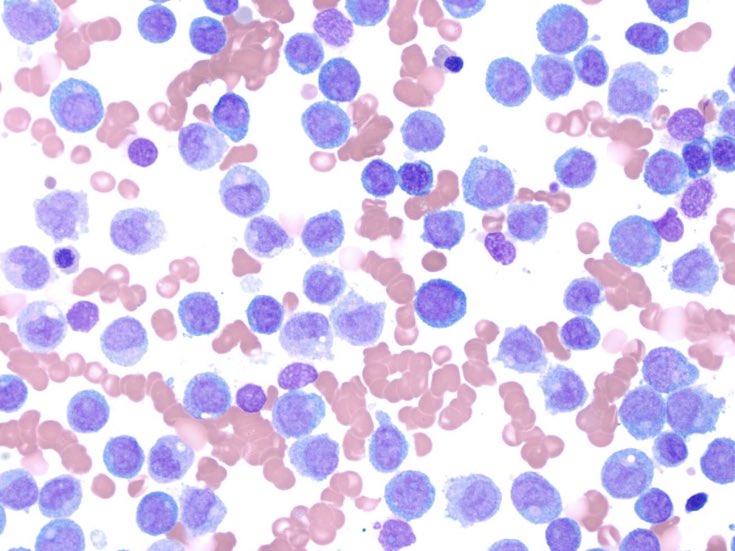
Cleveland Clinic Pathology Residency tweet media

L. Ashley Duckworth, MD
20 posts

L. Ashley Duckworth, MD
@LADuckMD
Cleveland Clinic Breast Pathology Fellow Dog mom All opinions are my own


Meet our loudest resident- @LADuckMD. Ashley grew up in Louisville, KY and attended @WSUBoonshoftSOM for medical school. When not previewing, you can find her playing on patios with her Pit Bull, Jordie Duke... instagram.com/p/CGpk-Y4DKSC/… #PathMatch21 #ccfpathres #meettheresidents








It turns out dogs really like you when you’re eating a signature #nanobrewcle burger made with 100% certified angus beef. 🐶🍔 Come visit us tonight on the #dogfriendlypatio. We’re open until 11pm, cheers!







Signout today starts at 11! Prior to signout, residents dictate the cases, fill out synoptics, and map the radical prostatectomies. During signout, staff review all aspects of the case. When all is done, the case goes back to resident’s box to review the final! @FrozenSections





The Pathologist's 2020 Power List is now live! Will you appear in one of this year's four categories? Will your friends, colleagues, family? Find out now! #PathPower20 thepathologist.com/power-list/2020

Today’s #meettheresidents is PGY-4 Gabriel Oaxaca. Gabriel is from El Paso, Texas and attended Baylor College of Medicine in Houston, Texas. Gabriel served as AP Co-Chief during the 2019-2020 academic year. He will… instagram.com/p/CDOeb8PDuIo/…







What can we say, we go through a lot of fruit during bootcamp! This morning kiwis acted as improperly oriented lumpectomies and our first years had to figure out how to properly orient, ink, and cassette! Led by the fabulous Dr. J. Jordi Rowe. #CCFpathres